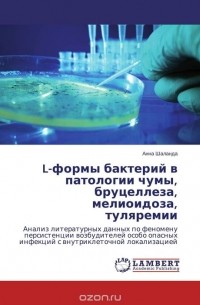
Обложка

Книга состоит из коротких очерков, посвященных врачам, борющимся со смертельными заболеваниями.
Джейн Кроув, несколько лет назад нечаянно пустившая чуму в современный мир, и ее сын Алекс, с которым связаны ее величайшие надежды и величайшая тайна, нашли приют в одном...
И. Куренков в своей документальной повести воскрешает подвиг русских медиков, принимавших активное участие в борьбе с чумой, эпидемия которой возникла в 1910—1911 гг. в Ма...
Вирусы и бактерии во все времена были главным врагом человечества. Войны и стихийные бедствия никогда не уносили столько жизней, сколько эпидемии. Даже сейчас, несмотря н...
Непрошеная гостья Европы XIV-XV веков, Чёрная смерть врывается во дворцы и скромные лачуги Флоренции, губя на своём пути как зажиточных, так и обездоленных. Не зная истинн...
В монографии рассматриваются теоретические аспекты, методика изучения пространственной структуры чумных эпизоотий и морфология природных очагов этой инфекции. Многие вопро...
В монографии проделан всесторонний анализ эпизоотологической и эпидемиологической структуры эндемии чумы в природном Среднеазиатском пустынном очаге этой ...
Успехи последних десятилетий в области микробиологии показали, что наши прежние представления о возбудителях заболеваний, формах их существования в природе, их этиологичес...
Аргентина. В 1956 году театр "Фрай Мочо" в Буэнос-Айресе поставил драму Освальдо Драгун "Чума идёт с Милоса". В ней события, происходившие в Древней Греции, были перенес...
Наградные медали Российской империи с надписью на реверсе: "За прекращение чумы в Одессе. 1837" очень редки и подлинные экземпляры в серебре хранятся только в крупнейших н...
Обладающий природным даром наводить страх на разбойников, превращая их оружие в ненужный атрибут униформы, смешно сказать, плевком слюны, насильно удерживаемый в башне сме...
Знаменитый роман Моэма ""Узорный покров"" — полная трагизма история любви, разворачивающаяся в небольшом городке в Китае, куда приезжают бороться с эпидемией холеры молодо...
История любви, побеждающей все - время и пространство, жизненные невзгоды и даже несовершенство человеческой души.
Смуглая красавица Фермина отвергла юношескую любовь др...
Только любовь может совершить настоящее чудо. Даже в самые тяжелые, жестокие времена она дарит людям надежду. Даже тогда, когда мир вокруг погружен во тьму и хаос, она рас...
Встреча чумы с холерою, или Внезапное уничтожение замыслов человеческих
Орлов Александр Анфимович
0
(0)Июнь 1944 года. До высадки союзников в Нормандии остаются считаные дни. Результат этой военной операции и исход Второй мировой зависит от того, удастся ли американскому вр...
Это первое на русском языке обстоятельное и систематизированное изложение истории загадочного природного явления, с глубокой древности называемого "чумой". В книге приведе...
"Город Чумы" ("The city of the Рlague"),-драматическая поэма Джона Вильсона (1785-1854), одного из видных поэтов "озёрной школы", - послужила, как известно, источником пуш...
Пожалуй, в истории человечества нет более оболганной и окруженной бесчисленными мифами эпохи, чем Средневековье. Период, который, по мнению значительной части историков, п...